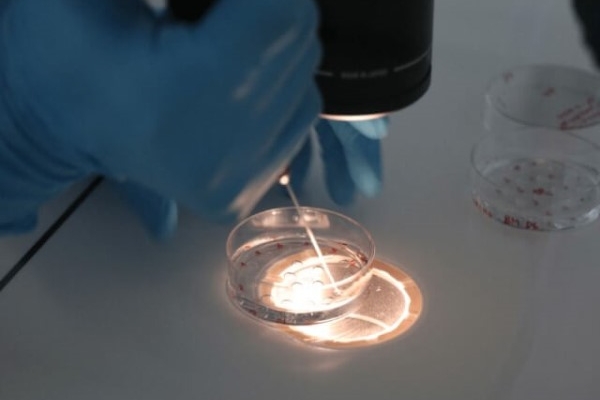
泰国DHC生殖医院:三代试管与二代试管成功率与技术区别的深度解析

-
高龄女性因卵巢功能衰退、卵子质量下降等问题,试管婴儿成功率普遍低于年轻群体。然而,通过科学干预与综合管理,仍可显著提升妊娠成功率。其中,胚…2026-01-26
-
在杭州三代试管婴儿技术中,精准把控“加精”时机是提高试管婴儿成功率的关键。通过控制性促排卵、精准选择“加精”时机以及应对特殊情况等措施,医…2026-01-23
-
格鲁吉亚universe三代试管婴儿技术的成功率受到多种因素的影响。夫妇双方在选择治疗前应充分了解相关知识,做好充分的准备,积极配合医生的治疗方案…2026-01-23
-
美国BHF生育中心三代试管婴儿技术以基因筛查为核心,结合个性化方案与高精度培养,为高龄女性、遗传疾病家庭及反复失败患者提供生育新路径。从前期…2026-01-23
-
试管婴儿移植囊胚后的着床时间虽然因人而异,但通过先进的医疗技术和个性化的治疗方案,我们可以大大提高着床成功率。马来西亚爱维生育中心凭借其三…2026-01-23
-
在试管婴儿的过程中,促排卵是一个至关重要的环节。然而,关于试管促排是否会导致胚胎染色体异常的问题,一直以来都备受关注。本文将结合相关研究和…2026-01-23
-
试管婴儿技术作为现代生殖医学的重要组成部分,为无数不孕不育家庭带来了生育的希望。其中,二代试管和三代试管作为先进的辅助生殖技术,各自具有独…2026-01-23
-
在辅助生殖技术中,养囊(即将受精卵培养至囊胚阶段)是一个关键步骤,旨在筛选出更具发育潜力的胚胎,从而提高移植成功率。然而,面对胚胎质量不佳…2026-01-23
-
试管婴儿技术为许多不孕不育的夫妇带来了福音,但胚胎移植的数量一直是备受关注的问题。特别是35岁的女性,她们在选择试管婴儿时,对于应该移植多少…2026-01-23
-
达必佳(醋酸曲普瑞林注射液)常用于试管婴儿治疗中的降调节阶段,通过抑制垂体分泌促性腺激素,调控激素水平,为后续促排卵和胚胎移植创造条件。在…2026-01-23
-
试管婴儿技术为许多不孕不育家庭带来了希望,囊胚移植更是提高了成功率。然而,囊胚着床后突然胎停的情况依然时有发生,给期待中的家庭带来沉重的打…2026-01-22
-
随着现代医疗技术的进步,越来越多的高龄夫妇选择通过试管婴儿技术实现生育愿望。然而,随着年龄的增长,女性的生育能力自然下降,卵泡质量成为影响…2026-01-22
-
在辅助生殖技术领域,冻胚移植作为一种常见的治疗手段,被广泛应用于解决不孕不育问题。然而,关于冻胚移植前是否需要降调,这一问题的答案并非一成…2026-01-22
-
黄体期促排方案是一种在黄体期进行试管促排卵治疗的方法,它通过使用促性腺激素等药物刺激卵巢,帮助获取多个优质卵子。在这一方案中,孕酮片(如安…2026-01-22
-
试管移植后,部分女性会遭遇脸上突然爆痘的困扰,这一现象虽常见,却常引发对移植结果的担忧。实际上,脸上爆痘与移植成功与否并无直接关联,而内分…2026-01-22
-
试管婴儿的成功率是卵子数量、质量与医疗技术共同作用的结果。马来西亚爱维生育中心通过科学平衡数量与质量,结合个性化方案与先进技术,为患者提供…2026-01-21
相关文章
- 驼奶粉什么牌子是正宗的?国内口碑最好的7款骆驼奶品牌供你参考 2022-09-01
- 女人梦见猫的七大预兆,看完就知道准不准 2023-04-20
- 注意女人裸睡三大忌,不注意就会让疾病找上门 2023-05-17
- 女人梦见蛇的七大预兆,快对照看看准不准 2023-04-27
- NT单子上有男女标志!三秒钟分清男宝女宝! 2022-08-22
- 2022央视曝光34种有毒尿不湿,选错了纸尿裤对宝宝是非常不利的 2022-09-04
- 女人梦见老鼠的七大预兆,快来看看是凶是吉 2022-10-17
- 清宫表2023年清宫图高清版,生男生女准确率高达90% 2023-04-13
- 优质资讯:皮肤过敏10种症状图片,赶紧对照自查一下 2022-09-06
- 十大最无用的兴趣班,作用不大还浪费钱 2022-10-19
- 孕囊形状看男女(超准),孕囊三个数据看男女方法解读 2023-07-04
- 5个姿势夹的男人爽,让男人欲罢不能的同房体位 2023-06-07
- XXX综合征(超雌综合征)是什么?一种性染色体异常的疾病 2022-01-28
- 4种胎位图解,孕30周这个姿势最适合顺产 2022-01-28
备孕优生
助您好孕多多